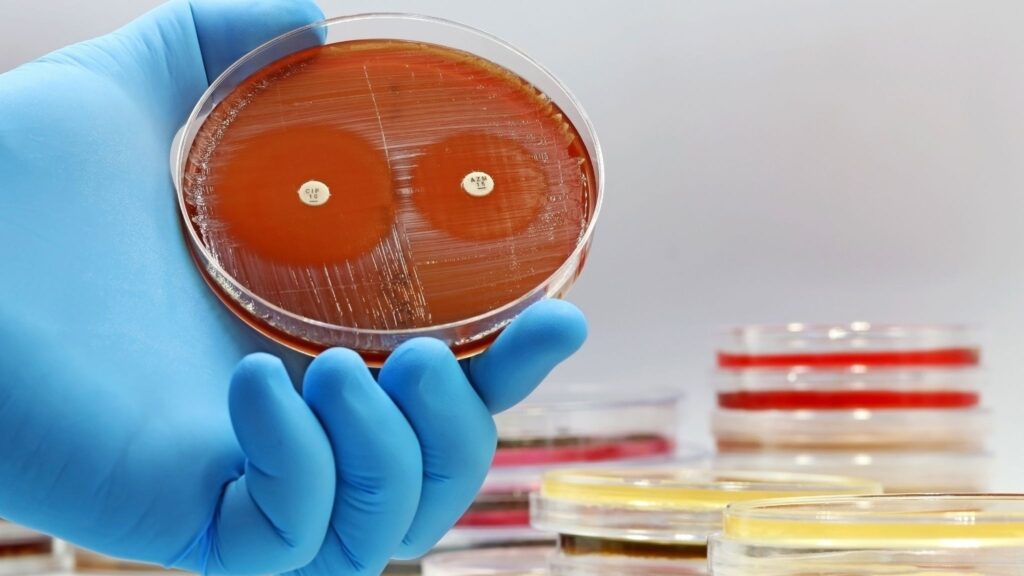
Novo alvo pode tornar antibióticos mais eficazes contra bactérias. (Foto: Getty Images via Canva)
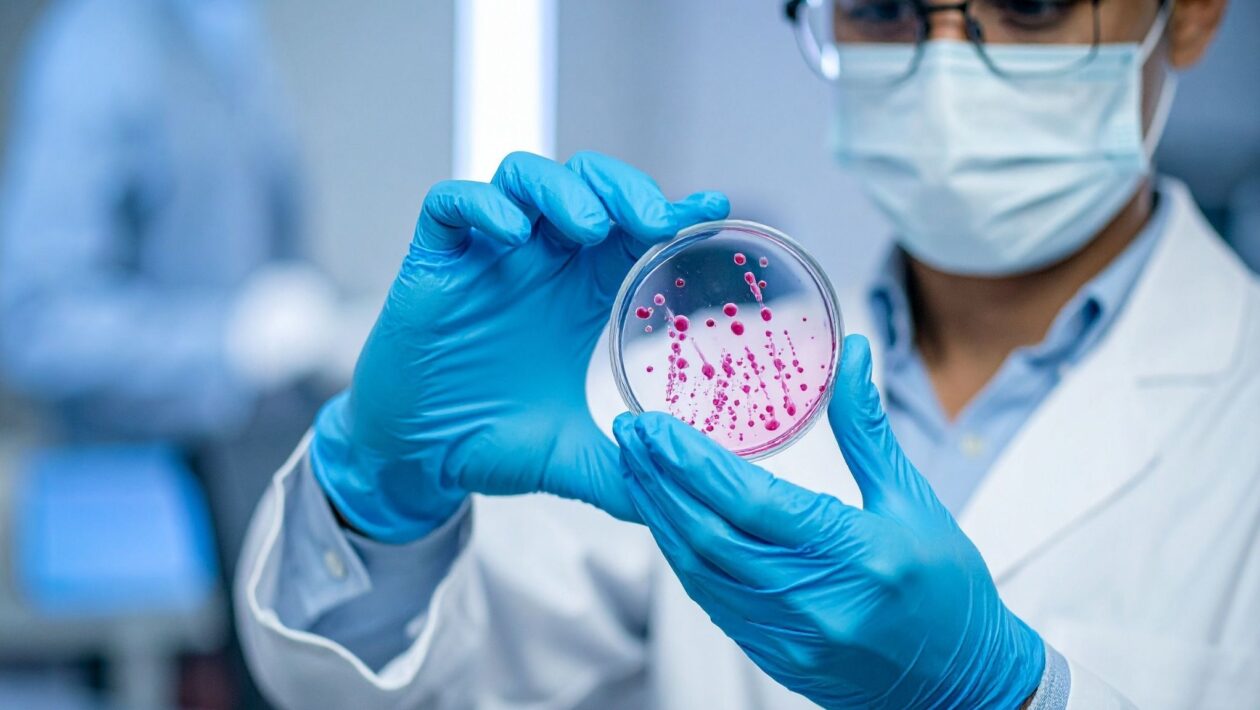
Sistema Rtc ajuda bactérias a sobreviver aos antibióticos. (Foto: TrueCreatives via Canva)

A resistência bacteriana segue desafiando a medicina moderna, e um novo estudo da Universidade de Edimburgo acaba de revelar mais um motivo para isso. Pesquisadores descobriram que algumas bactérias contam com um sistema interno de reparo, conhecido como Rtc, que lhes permite resistir à ação de antibióticos usados há décadas.
Essa descoberta, publicada na revista Nature Communications, pode abrir caminho para terapias mais eficazes no combate a infecções resistentes.
Um escudo molecular contra antibióticos
Os antibióticos agem interrompendo a produção de proteínas vitais que mantêm as bactérias vivas. No entanto, o novo estudo mostrou que o sistema Rtc consegue corrigir o RNA danificado durante esse processo, permitindo que as células bacterianas continuem funcionando mesmo sob ataque.
Em outras palavras, enquanto o medicamento tenta bloquear a síntese de proteínas, o Rtc entra em ação, reparando as falhas e preservando o crescimento bacteriano. Essa habilidade torna algumas infecções muito mais difíceis de eliminar, especialmente em organismos como a Escherichia coli, conhecida por desenvolver resistência rapidamente.
O papel da variabilidade celular
Um dos achados mais interessantes foi que o sistema Rtc não se comporta de forma idêntica em todas as bactérias. Em algumas células, ele é altamente ativo; em outras, quase inexistente. Essa diferença de expressão explica por que, dentro de uma mesma infecção, algumas bactérias morrem e outras sobrevivem ao tratamento.
Essa variabilidade confere uma vantagem evolutiva às populações bacterianas, já que permite que parte delas resista aos antibióticos e volte a se multiplicar após o tratamento. Esse fenômeno ajuda a entender por que certas infecções parecem “voltar” mesmo após o uso correto dos medicamentos.
Caminho promissor para novos tratamentos
Os pesquisadores usaram modelos computacionais e experimentos laboratoriais para compreender como o sistema Rtc atua e quais são suas principais vulnerabilidades. O próximo passo é desenvolver novos fármacos que bloqueiem esse mecanismo de reparo, tornando os antibióticos existentes novamente eficazes.
Essa estratégia, em vez de criar antibióticos totalmente novos, pode potencializar os medicamentos atuais, reduzindo o custo e o tempo de desenvolvimento. Além disso, direcionar o tratamento para o sistema Rtc pode diminuir a chance de novas mutações resistentes surgirem.
Um passo à frente na luta contra a resistência antimicrobiana
A resistência antimicrobiana (RAM) é considerada uma das maiores ameaças à saúde global. Estima-se que, até 2050, as infecções resistentes possam causar milhões de mortes por ano se novas estratégias não forem implementadas.
Ao compreender os mecanismos de defesa bacteriana com maior profundidade, os cientistas esperam desenvolver terapias mais inteligentes e direcionadas, capazes de preservar a eficácia dos antibióticos que já temos.
A descoberta do sistema Rtc é um avanço importante nessa corrida científica, mostrando que entender como as bactérias se defendem pode ser a chave para vencer essa batalha microscópica.